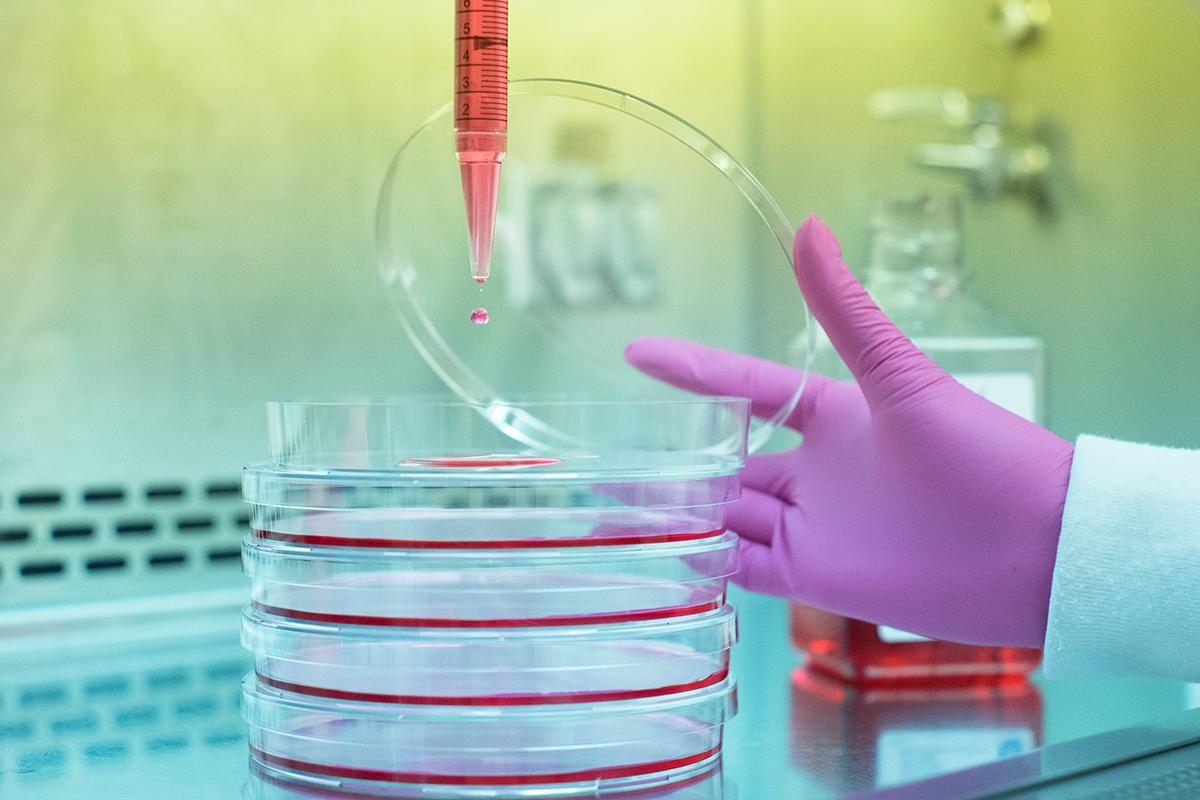
Opening a case for liquid drops

Strategic Research Plan
From Idea to Impact, the 2023–2028 University of Guelph Strategic Research Plan, refreshes and refines the most effective components of its predecessor, ensuring the new plan’s ongoing relevance and increasing our effectiveness at achieving our institutional goals.
Designed with the priorities of Our Time, the U of G 2022–2027 Strategic Plan, in mind, From Idea to Impact reinforces fundamental institution‑wide goals with a focus on driving the U of G research enterprise forward.
There are four components to implementing the overall plan:
- Disciplines and themes to identify priority areas for investment, intervention and other initiatives
- Principles and goals, with associated key performance indicators, to guide decision‑making
- Considerations of equity, diversity, inclusion and indigenization threaded throughout the plan
- A clear system of accountability
You can also view a summary of our Strategic Research Plan submitted to the Canada Research Chairs Program to support our nominations by demonstrating to reviewers how we will use funding from the Chairs to attract and retain world-class experts.
Research Disciplines
- Comprehensive
- Our comprehensive research strengths include the humanities, creative arts, social sciences, life sciences, physical sciences, engineering and medicine.
- World-Class
- In our pursuit of excellence, our researchers have become leaders in their disciplines, nationally and globally.
- Dynamic
- Always exploratory, our researchers constantly seek new opportunities for discovery, creating transdisciplinary and interdisciplinary areas of scholarship.

Arts, Humanities and Social Sciences
Our research spans the liberal arts, creative and critical practices, and social sciences to enhance the health and well-being of families and society. Through interdisciplinary inquiry, we explore history, literature, philosophy, languages and the arts while addressing pressing issues like social justice, identity, environmental responsibility and the impact of technology.

Science, Technology, Engineering and Mathematics (STEM)
U of G's STEM research explores the universe and living systems, applying new knowledge to real-world challenges. With expertise in microbiology, biodiversity, nanotechnology, quantum information and engineering, our research drives innovation and collaboration locally and globally.

Agriculture
The University has a strong foundation in agricultural research, globally recognized for its impact on food science, safety and sustainability. Our faculty advance precision agriculture, crop and livestock development and shape Canada’s agri-food industry through innovation and policy. Partnering with the Ontario Ministry of Agriculture, Food and Agribusiness, we ensure research translates into real-world solutions.

Veterinary Medicine
The University, built on the strengths of the Ontario Veterinary College, is a global leader in veterinary medicine, advancing research from molecular and cellular processes to population health. Our work impacts companion animal and livestock welfare worldwide, with unique expertise in comparative medicine.

Business
U of G tackles global challenges through ethical research, advancing business as a force for good. Our work spans three areas: developing theories in fields like economics and marketing, supporting industries such as agribusiness and tourism and improving professional practices in finance, accounting and management.
Research Themes
- Differentiated
- Historical research strengths established by our three founding colleges created a foundation of unique, highly reputed expertise upon which we have grown critical mass and global excellence.
- Cross-Cutting
- Our research themes transcend disciplines, bringing our comprehensive strengths to address challenges requiring a broad lens and a critical mass of research strength.
- Cutting-Edge
- Our research themes place a premium on discovery, creativity and innovation to expand the frontiers of knowledge, propel knowledge into action and address some of the most critical challenges of our time — all to improve life.

Fundamental: Discovery
The University’s fundamental research builds an understanding of the continuum between curiosity-driven, discovery-based exploration of the properties of the universe and living systems on the one hand and the application of that knowledge and wisdom to real-world problems on the other.

The Environment
Research into biodiversity, ecology and the environment are core areas of distinction for U of G, where we target our efforts at addressing UN Sustainable Development Goals. The University places particular emphasis on soil, water and air quality, providing a strong foundation for their preservation and wise, sustainable management.
Applied: Innovation and Creation
Our researchers are solving problems through the production and analysis of novel innovations, be they technological or cultural forms, and in doing so, expanding the boundaries of practice-based research. Practice-based research at the University of Guelph has produced important discoveries in interdisciplinary areas and demonstrated leadership in using arts-based inquiry, techniques and responses to address societal issues.

One Health
One Health is an interdisciplinary framework focused on the complex interconnectedness between human, animal, and environmental health and welfare. Within One Health, U of G researchers work across disciplines and sectors to interrogate the biological and social factors that impinge on the health of organisms, from the level of molecules to that of ecosystems, with unique strengths in comparative medicine.

Food
Research on food spans all seven colleges and is embedded across multiple disciplines at the University. Food research at U of G extends from the fundamental chemistry of food stuffs to the private and public decisions that impact food production, food safety, food distribution and the business of food, and ultimately, to the impact of food production on ecosystems, the economy and society.
Research Principles and Goals
Purpose-driven. Long-term. Forward focused. Actionable. Measurable.
The research strategy is motivated by five principles that each generate a corresponding goal. Our institutional research goals are rooted in our mission to improve life. Our success in pursuing these overarching goals will be assessed through relevant Key Performance Indicators (KPIs), as detailed below.
